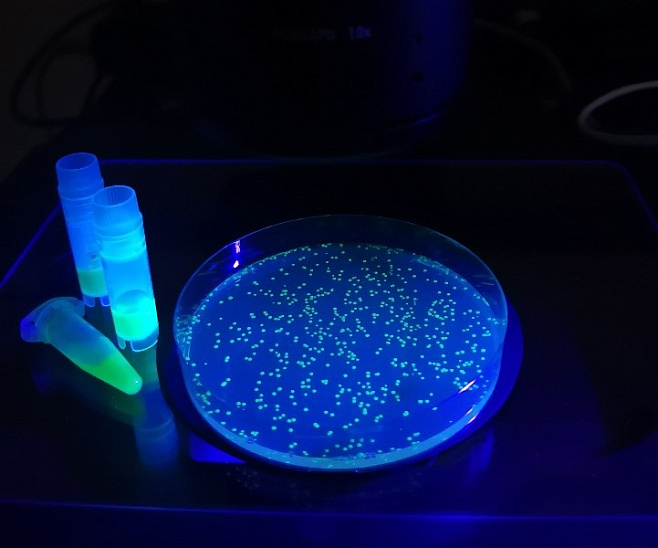

Создана система отслеживания воспалительного процесса в тканях

Как известно, в ответ на присутствие в организме патогенов иммунная система запускает процесс воспаления. Первой линией обороны организма являются некоторые специализированные клетки, особенно нейтрофилы и макрофаги. Они поглощают патогенные агенты, а также продукты распада собственных повреждённых тканей. Для этого они выделяют соединения с высокой реакционной способностью.
«Поразительно, что клетки нашего организма могут производить даже такое агрессивное соединение, как гипохлорит анион, в быту это вещество мы называем хлоркой. Помимо активных форм хлора в организме вырабатываются и другие соединения со схожими химическими свойствами, которые можно объединить в общую группу гипогалогенных кислот и их производных», — рассказывает Дмитрий Билан, руководитель проекта по гранту РНФ, кандидат биологических наук, руководитель группы метаболических основ патологии ИБХ РАН.
В норме гипогалогенные кислоты выполняют защитную функцию. Но при нарушениях регуляционных механизмов иммунные клетки могут послужить причиной развития гипогалогенного стресса. Последний приводит к повреждению тканей и дисфункции органов.
Российские и зарубежные исследователи создали уникальную технологию, которая поможет отслеживать динамику гипогалогенных кислот. Система состоит из двух частей: сенсорной и флуоресцентной. При колебаниях концентрации гипогалогенных кислот свечение биосенсора изменяется, что и позволяет понять их динамику.
Биосенсор кодируется геном, а значит может быть доставлен в клетки почти любых типов. Доказать эффективность устройства учёным удалось на примере рыб данио-рерио. Кроме того, исследователи смогли в реальном времени визуализировать динамику гипогалогенного стресса в бактериях, захваченных человеческими нейтрофилами.
«Большинство патологических процессов сопровождается развитием воспалительных реакций. Поэтому создание новых инструментов для исследований в этой области имеет важное значение не только для понимания механизмов в основе того или иного заболевания, но и для разработок терапии лечения. Кроме того, наш инструмент интересен для поиска новых физиологических функций гипогалогенных кислот и их производных», — отмечает Дмитрий Билан.
Фото: Дмитрий Билан
Наука
Антон Тальский


 Чёрная дыра в центре Млечного Пути испускает непериодические вспышки
Чёрная дыра в центре Млечного Пути испускает непериодические вспышки Микроорганизмы на носителе эффективно очищают сточные воды
Микроорганизмы на носителе эффективно очищают сточные воды








